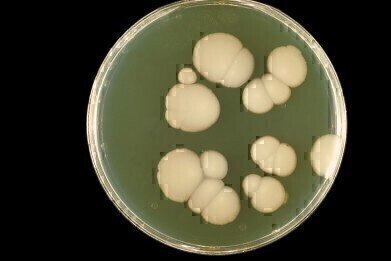
New Formulation Fungal Susceptibility Card to include Micafungin

Laboratory products
New Formulation Fungal Susceptibility Card to include Micafungin
Jul 19 2013
bioMérieux has created a new Fungal Susceptibility Card for susceptibility testing of Candida species and Cryptococcus neoformans. The VITEK 2 ASTYS07 card includes a sixth antifungal agent, micafungin, providing a valuable enhancement to antifungal susceptibility testing.
Yeast infections have become a major cause of morbidity and mortality in at-risk patient populations. Early diagnosis and prompt treatment are the key to achieving successful outcomes in these infections, and bioMérieux’s VITEK 2 instrument offers automated, standardised and rapid yeast susceptibility testing. The VITEK 2 AST-YS07 Fungal Susceptibility Card, which replaces VITEK 2 AST-YS06, complements the current antifungals – amphotericin B, caspofungin, fluconazole, flucytosine and voriconazole – with micafungin, an echinocandin active against Candida species, further extending the capabilities of the VITEK 2 and helping to ensure that the correct treatment is swiftly initiated.
Digital Edition
Lab Asia Dec 2025
December 2025
Chromatography Articles- Cutting-edge sample preparation tools help laboratories to stay ahead of the curveMass Spectrometry & Spectroscopy Articles- Unlocking the complexity of metabolomics: Pushi...
View all digital editions
Events
Jan 21 2026 Tokyo, Japan
Jan 28 2026 Tokyo, Japan
Jan 29 2026 New Delhi, India
Feb 07 2026 Boston, MA, USA
Asia Pharma Expo/Asia Lab Expo
Feb 12 2026 Dhaka, Bangladesh